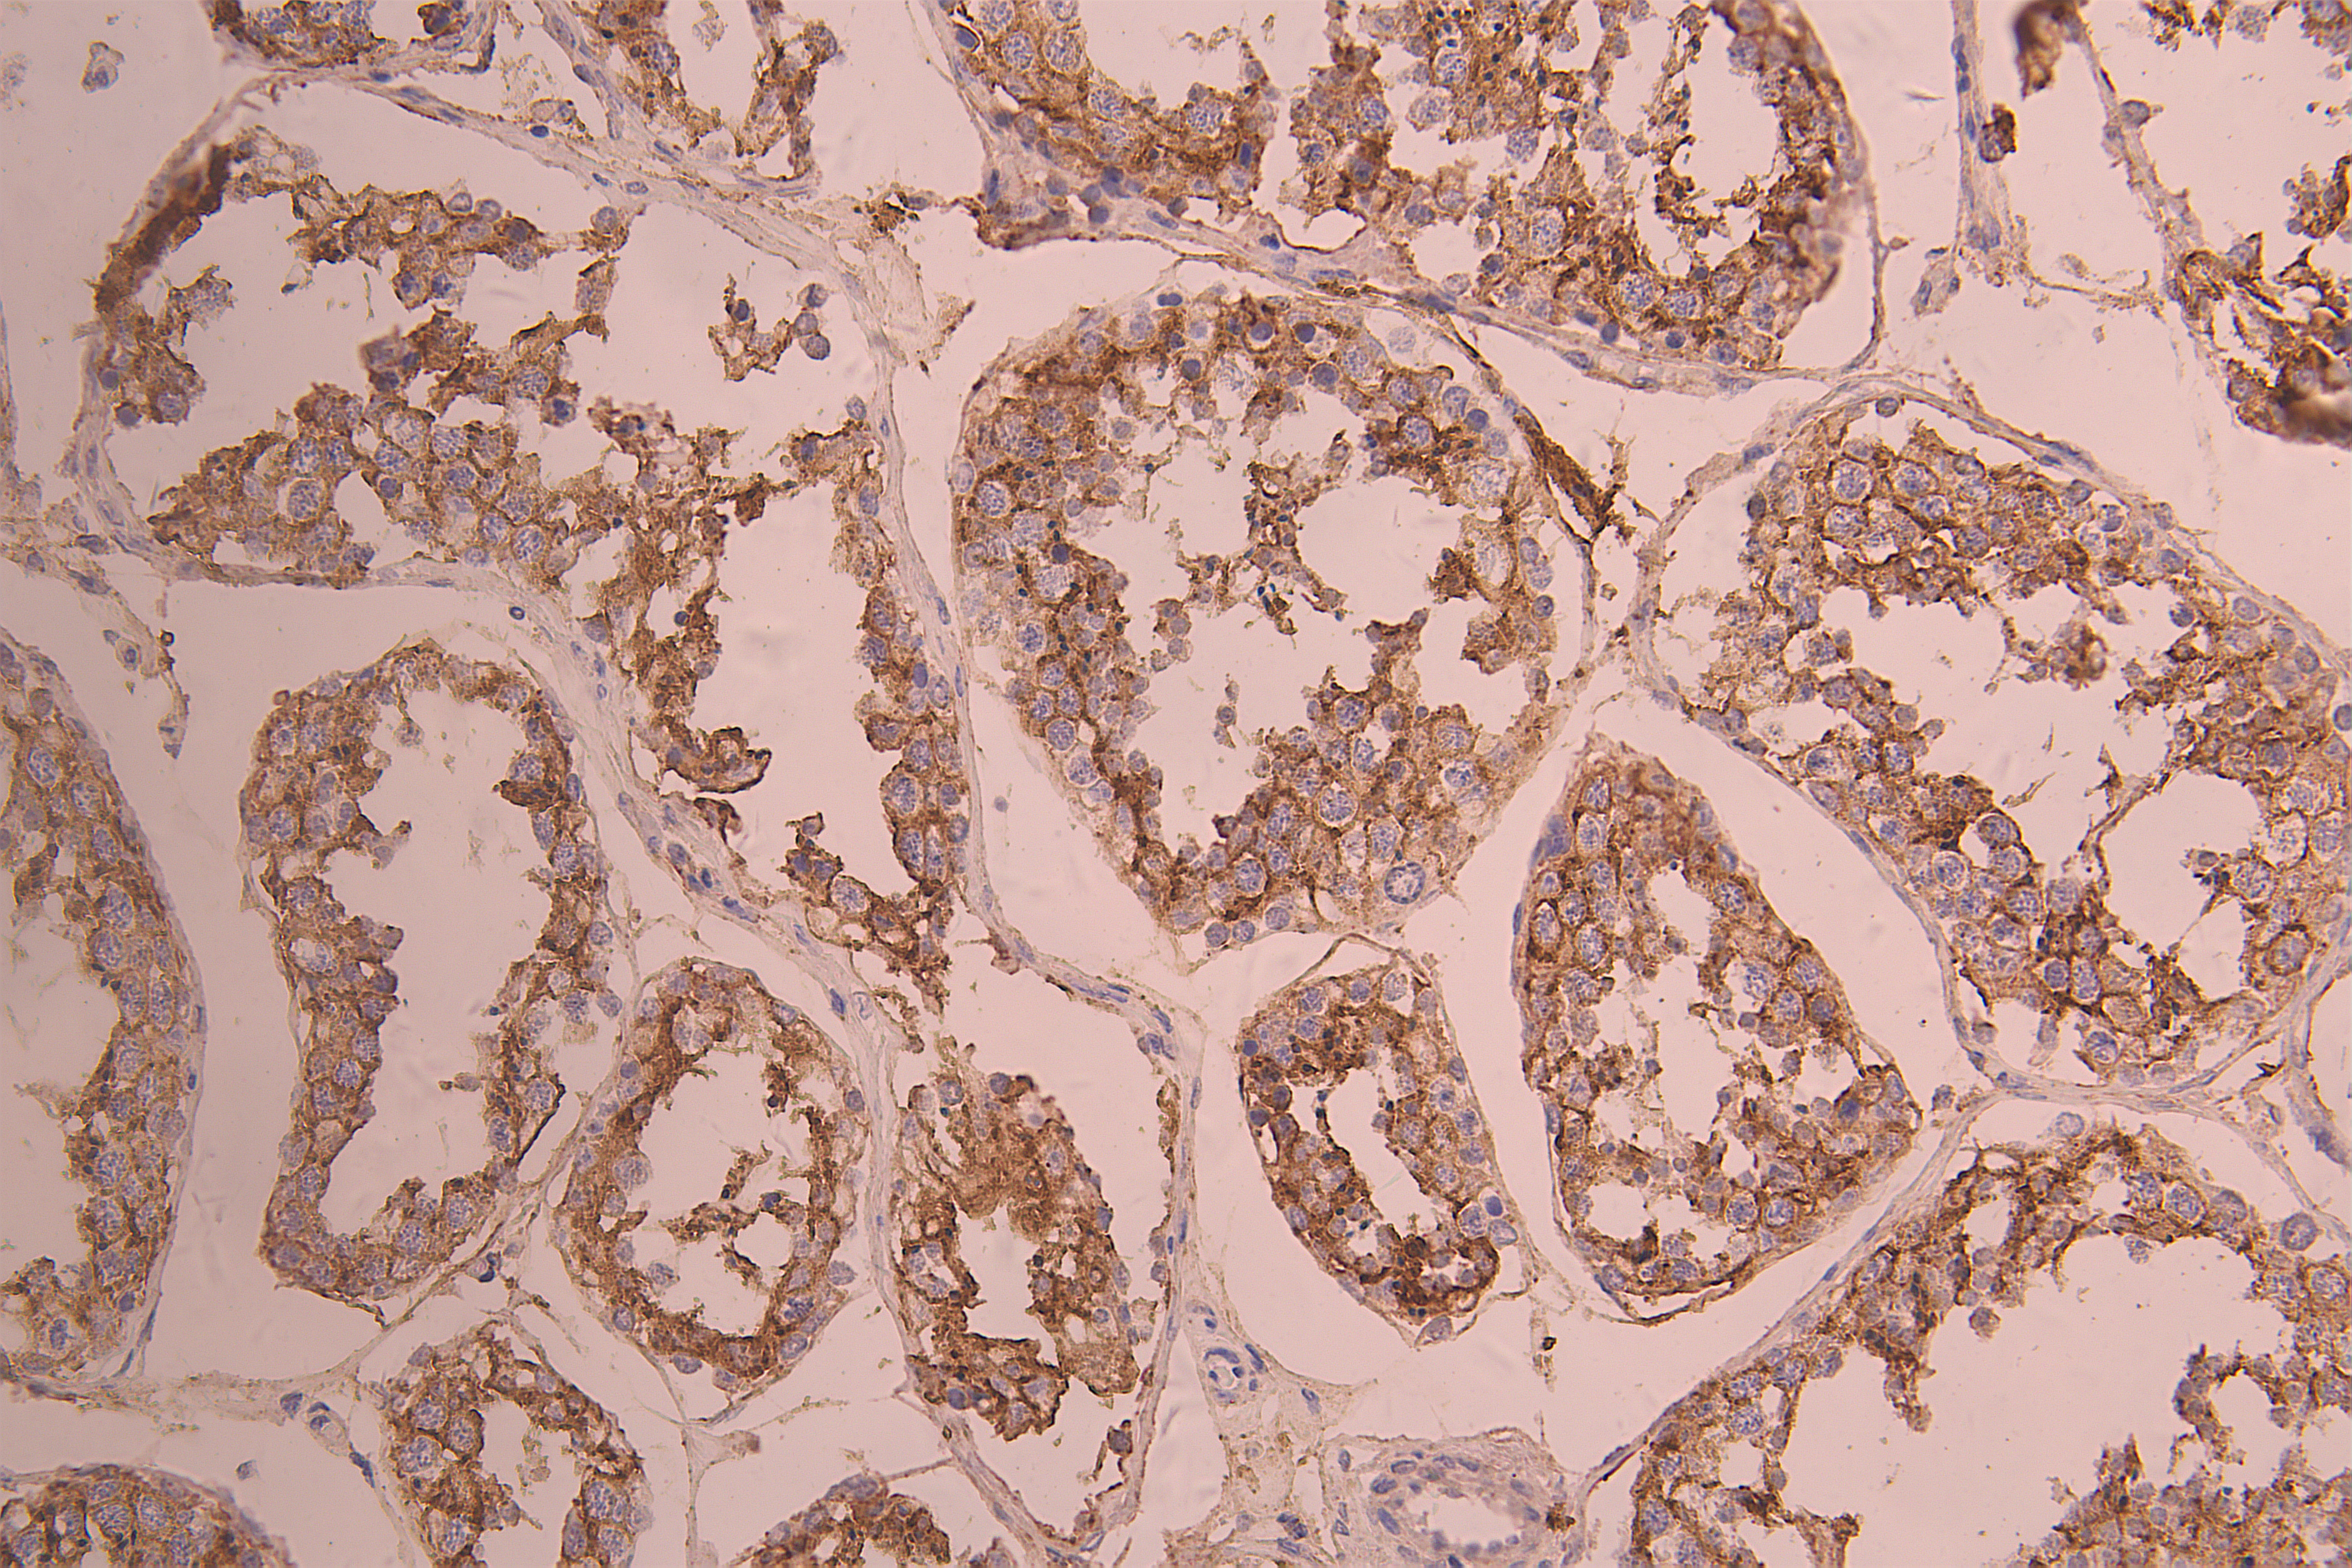

ACE2 Recombinant Monoclonal Antibody
-
中文名稱:ACE2 Recombinant Monoclonal Antibody
-
貨號:CSB-RA866317MA1HU
-
規格:¥1320
-
圖片:
-
IHC image of CSB-RA866317MA1HU diluted at 1:50 and staining in paraffin-embedded human testis tissue performed on a Leica BondTM system. After dewaxing and hydration, antigen retrieval was mediated by high pressure in a citrate buffer (pH 6.0). Section was blocked with 10% normal goat serum 30min at RT. Then primary antibody (1% BSA) was incubated at 4°C overnight. The primary is detected by a Anti-Human lgG, Fcy Fragment Specific labeled by HRP and visualized using 0.05% DAB.
-
IHC image of CSB-RA866317MA1HU diluted at 1:50 and staining in paraffin-embedded human small intestine tissue performed on a Leica BondTM system. After dewaxing and hydration, antigen retrieval was mediated by high pressure in a citrate buffer (pH 6.0). Section was blocked with 10% normal goat serum 30min at RT. Then primary antibody (1% BSA) was incubated at 4°C overnight. The primary is detected by a Anti-Human lgG, Fcy Fragment Specific labeled by HRP and visualized using 0.05% DAB.
-
-
其他:
產品詳情
-
Uniprot No.:
-
基因名:
-
別名:ACE 2 antibody; ACE related carboxypeptidase antibody; ACE-related carboxypeptidase antibody; ACE2 antibody; ACE2_HUMAN antibody; ACEH antibody; Angiotensin converting enzyme 2 antibody; Angiotensin converting enzyme homolog antibody; Angiotensin converting enzyme like protein antibody; Angiotensin I Converting Enzyme (peptidyl dipeptidase A) 2 antibody; Angiotensin I converting enzyme 2 antibody; Angiotensin-converting enzyme homolog antibody; DKFZP434A014 antibody; EC 3.4.17 antibody; metalloprotease MPROT 15 antibody; Metalloprotease MPROT15 antibody; OTTHUMP00000022963 antibody; Processed angiotensin-converting enzyme 2 antibody
-
反應種屬:Human
-
免疫原:Recombinant Human ACE2 protein
-
免疫原種屬:Homo sapiens (Human)
-
標記方式:Non-conjugated
-
克隆類型:Monoclonal
-
抗體亞型:hIgG1
-
純化方式:Affinity-chromatography
-
克隆號:16F6
-
濃度:It differs from different batches. Please contact us to confirm it.
-
保存緩沖液:Preservative: 0.03% Proclin 300
Constituents: 50% Glycerol, 0.01M PBS, PH 7.4 -
產品提供形式:Liquid
-
應用范圍:ELISA, IHC
-
推薦稀釋比:
Application Recommended Dilution IHC 1:50-1:200 -
Protocols:
-
儲存條件:Upon receipt, store at -20°C or -80°C. Avoid repeated freeze.
-
貨期:Basically, we can dispatch the products out in 1-3 working days after receiving your orders. Delivery time maybe differs from different purchasing way or location, please kindly consult your local distributors for specific delivery time.
-
用途:For Research Use Only. Not for use in diagnostic or therapeutic procedures.
相關產品
靶點詳情
-
功能:Essential counter-regulatory carboxypeptidase of the renin-angiotensin hormone system that is a critical regulator of blood volume, systemic vascular resistance, and thus cardiovascular homeostasis. Converts angiotensin I to angiotensin 1-9, a nine-amino acid peptide with anti-hypertrophic effects in cardiomyocytes, and angiotensin II to angiotensin 1-7, which then acts as a beneficial vasodilator and anti-proliferation agent, counterbalancing the actions of the vasoconstrictor angiotensin II. Also removes the C-terminal residue from three other vasoactive peptides, neurotensin, kinetensin, and des-Arg bradykinin, but is not active on bradykinin. Also cleaves other biological peptides, such as apelins (apelin-13, Non-functional as a carboxypeptidase.; (Microbial infection) Acts as a receptor for human coronaviruses SARS-CoV and SARS-CoV-2, as well as human coronavirus NL63/HCoV-NL63.; (Microbial infection) Non-functional as a receptor for human coronavirus SARS-CoV-2.
-
基因功能參考文獻:
- Report no influence of ACE2 gene polymorphism on stroke recurrence and only find possible interaction between hypertension history and the ACE2 gene in male stroke patients. PMID: 30056001
- In a Chinese Han population, five single-nucleotide polymorphisms (SNP) (rs1514283, rs4646155, rs4646176, rs2285666, and rs879922) in ACE2 gene were determined to significantly associate with essential hypertension in female participants, while no SNP locus was linked to male group. PMID: 30335025
- ACE2 and other enzymes can form ANG-(1-7) directly or indirectly from either the decapeptide ANG I or from ANG II. [review] PMID: 29351514
- Suggest a potential role for ACE2 polymorphism in postexercise hypotension in hypertensive medicated individuals. PMID: 27925380
- ACE2 SNPs and haplotypes are associated with circulating angiotensin-(1-7) levels. PMID: 28895159
- we found an interaction between ACE2 and AGTR1 in structuralatrial fibrillation patients in a Chinese Han population PMID: 29441892
- results suggest that ACE2, TNNI3K and CALM3 polymorphisms are associated with increased risk of hypertrophic cardiomyopathies and dilated cardiomyopathies and may act as disease modifiers of these diseases. PMID: 28744816
- Elevated plasma ACE2 is significantly associated with more advanced LA structural remodeling in atrial fibrillation. PMID: 27738071
- Overexpression of ACE2 in monocytes led to reduced endothelial adhesion, transmigration and downregulation of adhesion-related molecules and results in atherosclerosis. PMID: 28186543
- These results indicated that aberrant methylation of the ACE2 promoter may be associated with EH risk. In addition, sex may significantly influence ACE2 methylation. PMID: 28440441
- ACE2 rs2106809 is an important predictive factor of the response to antihypertensive treatment with ACE inhibitors in Chinese female hypertensive patients. PMID: 27121444
- In islets from db/db mice, ACE2 over-expression increased intracellular calcium influx and restored impaired mitochondrial oxidation, potentially causing an increase in GSIS. These results shed light on the potential roles of ACE2 in mitochondrial metabolism, moreover, may improve our understanding of diabetes. PMID: 29128354
- ACE2 may have a role in silent atherosclerosis in patients with chronic kidney disease; it counterbalances the vasoconstrictor adverse effects of angiotensin II by its conversion PMID: 27615597
- This study reveals an elevated serum concentration of ACE2 and independent associations between serum ACE2 and echocardiographic parameters in hypertensive patients. PMID: 28223093
- The findings of this study indicate that ACE-2 activity is reduced in AD and is an important regulator of the central classical ACE-1/Ang II/AT1R axis of renin-angiotensin system, and also that dysregulation of this pathway likely plays a significant role in the pathogenesis of Alzheimer's disease. PMID: 27884212
- Overexpression of ACE2 ameliorates Abeta-induced inflammatory response by activating the ACE2/Ang-(1-7)/Mas axis in human RPE cells. PMID: 28605813
- Although further studies are required to determine how clusterin suppresses non-specific cellular uptake in phagocytes, our data suggest that clusterin plays a key role in the stealth effect of not only pegylated nanoparticles but also non-pegylated nanoparticles. PMID: 27983983
- The ACE2 G8790A polymorphism in type 2 diabetes mellitus patients was correlated with cerebral stroke, and the A allele might be a risk factor of type 2 diabetes mellitus combined with cerebral stroke. PMID: 27500554
- ollectrin, an ACE2 homolog with no catalytic activity, regulates blood pressure through an NO-dependent mechanism. Large body of experimental data confirmed sustained beneficial effects of ACE2/Ang-(1-7)/Mas receptor axis activation on hypertension and vascular injury. PMID: 27889958
- The potential contribution of the ACE2 to cardiovascular disease progression was addressed. PMID: 27965422
- Serum ACE2 activity was significantly lower in acute ischemic stroke as compared to both control and stroke-alert patients, followed by an increase to control levels at three days. PMID: 27488276
- Here, we review the role and effects of ACE2, ACE2 activators, Ang-(1-7) and synthetic Mas receptor agonists in the control of inflammation and fibrosis in cardiovascular and renal diseases and as counter-regulators of the ACE-Ang II-AT1 axis. PMID: 26995300
- ACE2 overexpression inhibited cell growth. PMID: 27460845
- Downregulation of ACE2/Ang-(1-7)/Mas axis stimulates breast cancer metastasis through the activation of store-operated calcium entry and PAK1/NF-kappaB/Snail1 pathways. PMID: 27063099
- The circulating ACE2 and Ang-(1-7) levels were related to neither rs4646155 nor rs879922 in female or male patients.In conclusion, the rs2106809 polymorphism of the ACE2 gene may be a determinant of the circulating Ang-(1-7) level in female patients with hypertension, suggesting a genetic association between circulating Ang-(1-7) levels and ACE2 gene polymorphisms in patients with hypertension. PMID: 27310975
- These results indicated that angiotensin-(1-7)/ACE2/Mas axis may reduce liver lipid accumulation partly by regulating lipid-metabolizing genes through ATP/P2 receptor/CaM signaling pathway. PMID: 26883384
- ACE-2 significantly increased when IMR-90 were hypoxic prior to hyperoxic exposure with no recovery. PMID: 27093376
- Imbalanced down-regulation of ACE and ACE2 mRNA expression levels may play an important role in the development and progression of thoracic aortic aneurysmal dilatation and subsequently dissection. PMID: 25237166
- These results suggest that the ACE2 G8790A and rs2106809 polymorphisms may be associated with essential hypertension risk. PMID: 25237167
- ACE and ACE2 expression at the mRNA and protein levels are significantly increased in the myocardium of patients with heart failure. PMID: 25869724
- Multivariable regression analysis revealed that urinary L-FABP and urinary albumin/ creatinine ratio were significantly associated with urinary ACE2 levels. PMID: 26067610
- ACE2 and Ang-(1-7) significantly inhibit early atherosclerotic lesion formation via protection of endothelial function and inhibition of inflammatory response. PMID: 25721616
- ACE-2 is expressed in fetal human lung fibroblasts but is significantly decreased by hyperoxic gas PMID: 25665060
- urinary ACE2 increased in type 2 diabetic patients with various degrees of albuminuria PMID: 25791940
- soluble ACE2 is involved in the pathomechanism of hypertension and heart failure. PMID: 24691269
- Decrease in circulating ACE2 activity was associated with cardiovascular disease in patients with chronic kidney disease. PMID: 25813276
- By genetic replenishment of ACE2 and pharmaceutical use of ARB, restored ACE2 level mitigated GBC growth. Our results supported the rationale for the use of ARB in GBC patients for potential therapeutic benefit PMID: 25663464
- There is no clear association between ACE2 gene A9570G polymorphisms and childhood primary nephrotic syndrome. PMID: 25815490
- Our results revealed that SNPs rs2074192 and rs714205 in ACE2 gene were associated with the susceptibility of DR and PDR. PMID: 25359286
- Olmesartan may uniquely increase urinary ACE2 level in hypertensive patients, which could potentially offer additional renoprotective effects. PMID: 24842388
- Hepatocellular carcinoma patients with higher level of ACE2 expression had longer survival time than those with lower level of ACE2 expression. PMID: 25701390
- Urinary ACE2 activity and protein expression are increased in type 1 diabetes patients prior to the onset of clinical complications. PMID: 24920267
- Brain endoplasmic reticulum stress does not contribute to DOCA-salt hypertension and ACE2 blunts neurogenic hypertension independently of ER stress. PMID: 25519733
- Partial loss of ACE2 is sufficient to enhance the susceptibility to heart disease. PMID: 24728465
- These data demonstrate that MSCs modified to overexpress the ACE2 gene can produce biologically active ACE2 protein over a sustained period of time and have an enhanced ability to promote endothelial repair after LPS challenge PMID: 25200929
- ACE2 cleavage is regulated by influenza A H1N1 neuraminidase. PMID: 24662240
- among females ACE2 rs2106809 polymorphisms,and among males ACE2 rs2106809 polymorphism and alcohol consumption are associated with essential hypertension PMID: 24112034
- Data suggest angiotensin (ANG) converting enzyme 2/ANG-II-(1-7)/proto-oncogene protein Mas axis regulates inflammation/fibrosis, cell proliferation, and leukocyte recruitment/activation; main topic here is kidney/inflammatory renal disease. [REVIEW] PMID: 23488800
- ACE2 and FZD1 are prognosis markers in squamous cell/adenosquamous carcinoma and adenocarcinoma of gallbladder. PMID: 23921915
- ACE2 overexpression in the rostral ventrolateral medulla attenuates the enhanced tonically active glutamatergic input in SHRs, which may be an important mechanism underlying the beneficial effect of central ACE2 to hypertension. PMID: 24838502
顯示更多
收起更多
-
亞細胞定位:[Processed angiotensin-converting enzyme 2]: Secreted.; Cell membrane; Single-pass type I membrane protein. Cytoplasm. Cell projection, cilium. Apical cell membrane.; [Isoform 2]: Apical cell membrane.
-
蛋白家族:Peptidase M2 family
-
組織特異性:Expressed in endothelial cells from small and large arteries, and in arterial smooth muscle cells (at protein level). Expressed in enterocytes of the small intestine, Leydig cells and Sertoli cells (at protein level). Expressed in the renal proximal tubul
-
數據庫鏈接:
Most popular with customers
-
-
YWHAB Recombinant Monoclonal Antibody
Applications: ELISA, WB, IHC, IF, FC
Species Reactivity: Human, Mouse, Rat
-
Phospho-YAP1 (S127) Recombinant Monoclonal Antibody
Applications: ELISA, WB, IHC
Species Reactivity: Human
-
-
-
-
-